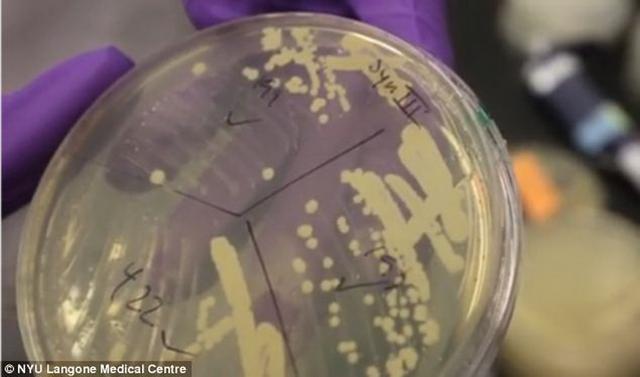

科学家最新研制一种合成酵母染色体,未来可应用于医学、疫苗,生物燃料等领域
目前,科学界朝向培育人造生命迈出了具有里程碑意义的重要一步!现已成功培育一种功能性合成酵母染色体。
这项研究突破了细菌和病毒的限制,在合成生物学领域获得了重大突破,科学家通过剥离“垃圾DNA”,改进了酵母染色体设计,并表示这项技术可赋予染色体新的属性。
虽然该研究尚处于初期阶段,创造的人造酵母菌株可用于医学、疫苗,甚至是生物燃料。染色体是微型DNA集合体,所包含的基因被称为“生命之书”,此前,科学家培育出人造细菌染色体,例如:病毒脱氧核糖核酸,但目前最新研究首次获得真核细胞染色体,一种较高等级微生物,其细胞不同于细菌,包含着细胞核。
不同于基因工程学,这项研究涉及到从一个有机体转换基因至另一个,合成生物学涉及到设计,之后从零开始构造新的基因物质。美国合成生物学先驱杰夫-博伊科(Jef Boeke)博士说:“我们的研究在合成生物学领域将理论变为现实!”
这项研究代表着国际协作构建合成酵母完整基因的一个重大进步,研究报告发表在《科学》杂志上,研究小组描述被称为“synIII”的染色体如何构建和成功结合到啤酒酵母中。(腾讯科学 悠悠)
新闻来源:http://life.kexue.com/2014/0331/38246.html



















留言